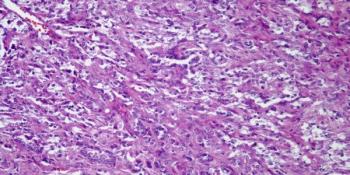

Genotyping of African Americans suggest that with regard to somatic driver mutations in non-small-cell lung cancer (NSCLC), black patients do not significantly differ from white patients, according to a new study.

Your AI-Trained Oncology Knowledge Connection!


Genotyping of African Americans suggest that with regard to somatic driver mutations in non-small-cell lung cancer (NSCLC), black patients do not significantly differ from white patients, according to a new study.

A population-based study found some evidence that the use of statins is linked to reduced rates of cancer-specific mortality among lung cancer patients.

Patients with lung cancer are increasingly receiving targeted therapies that induce complete disease remissions, but they can also develop resistance to these drugs. New efforts are now underway to discover and develop new options for patients experiencing drug resistance.

Inhibition of PD-1 with pembrolizumab was well tolerated and showed promising survival results in a large phase I trial of patients with advanced non–small-cell lung cancer (NSCLC).

Too many people are being screened, diagnosed, and treated for certain types of cancer, according to two cancer researchers.

Early-stage non–small-cell lung cancer patients over 70 years old derive a similar benefit as younger patients from adjuvant chemotherapy following surgical resection.

A 76-year-old man is found to have a right upper lobe mass. After further evaluation, a biopsy is performed. What is your diagnosis?
During routine chest imaging a 35-year-old woman is found to have a coin lesion in the right upper lobe. What is your diagnosis?

Though surgery is the standard treatment for early-stage non-small-cell lung cancer, a new study suggests that stereotactic body radiotherapy offers lower immediate mortality and toxicity.

In this interview we discuss the recent CMS decision to cover low-dose CT screening for lung cancer in patients who fit specific criteria.

Men with high midlife cardiorespiratory fitness have a lower incidence of lung and colorectal cancer; however, this association was not seen for prostate cancer.

A retrospective analysis showed that crizotinib is highly active in lung cancer with ROS1 rearrangements, which are present in about 1% of lung adenocarcinomas.

A study found varying degrees of costs and benefits associated with granting early access to drugs based on PFS. In many cases, costs outstripped the benefits.

The best management of distress in a lung cancer patient involves aggressive physical symptom control, attention to concerns about death, and psychosocial support for the patient and his or her caregivers, as well as management of more typical psychiatric symptoms.

A state of equipoise now exists for various surgical options in the treatment of early lung cancer, underscoring the need for shared decision making.

Smaller early-stage tumors may lend themselves to less radical lung parenchymal sparing resections or no surgery at all.

This review looks at the current data and guidelines for thoracoscopic resection of stage I NSCLC and discusses the potential for limited lung resection in patients with the disease.

The FDA has approved nivolumab (Opdivo) for the treatment of metastatic squamous non-small-cell lung cancer (NSCLC) in patients who have progressed on a platinum-based chemotherapy.

A retrospective analysis suggested that a declining proportion of patients with lung cancer would meet the criteria for undergoing low-dose CT screening.

In a phase II study, the use of maintenance sunitinib improved progression-free survival among patients with untreated extensive-stage small-cell lung cancer.

A classification system known as Lung-RADS reduced false positive rates but also decreased the sensitivity of low-dose CT screening compared with NLST standards.

Patients with lung and colorectal cancer who understood that chemotherapy would not cure them were no less likely to receive chemotherapy at the end of life.

In patients with diabetes, the use of metformin did not reduce the risk of lung cancer overall, but the risk was reduced among patients who never smoked.

The US Food and Drug Administration has granted orphan drug designation to tarextumab for the treatment of pancreatic cancer and small-cell lung cancer.

A study of nivolumab compared with docetaxel in patients with squamous cell NSCLC was stopped early after an analysis showed superiority of the study drug.